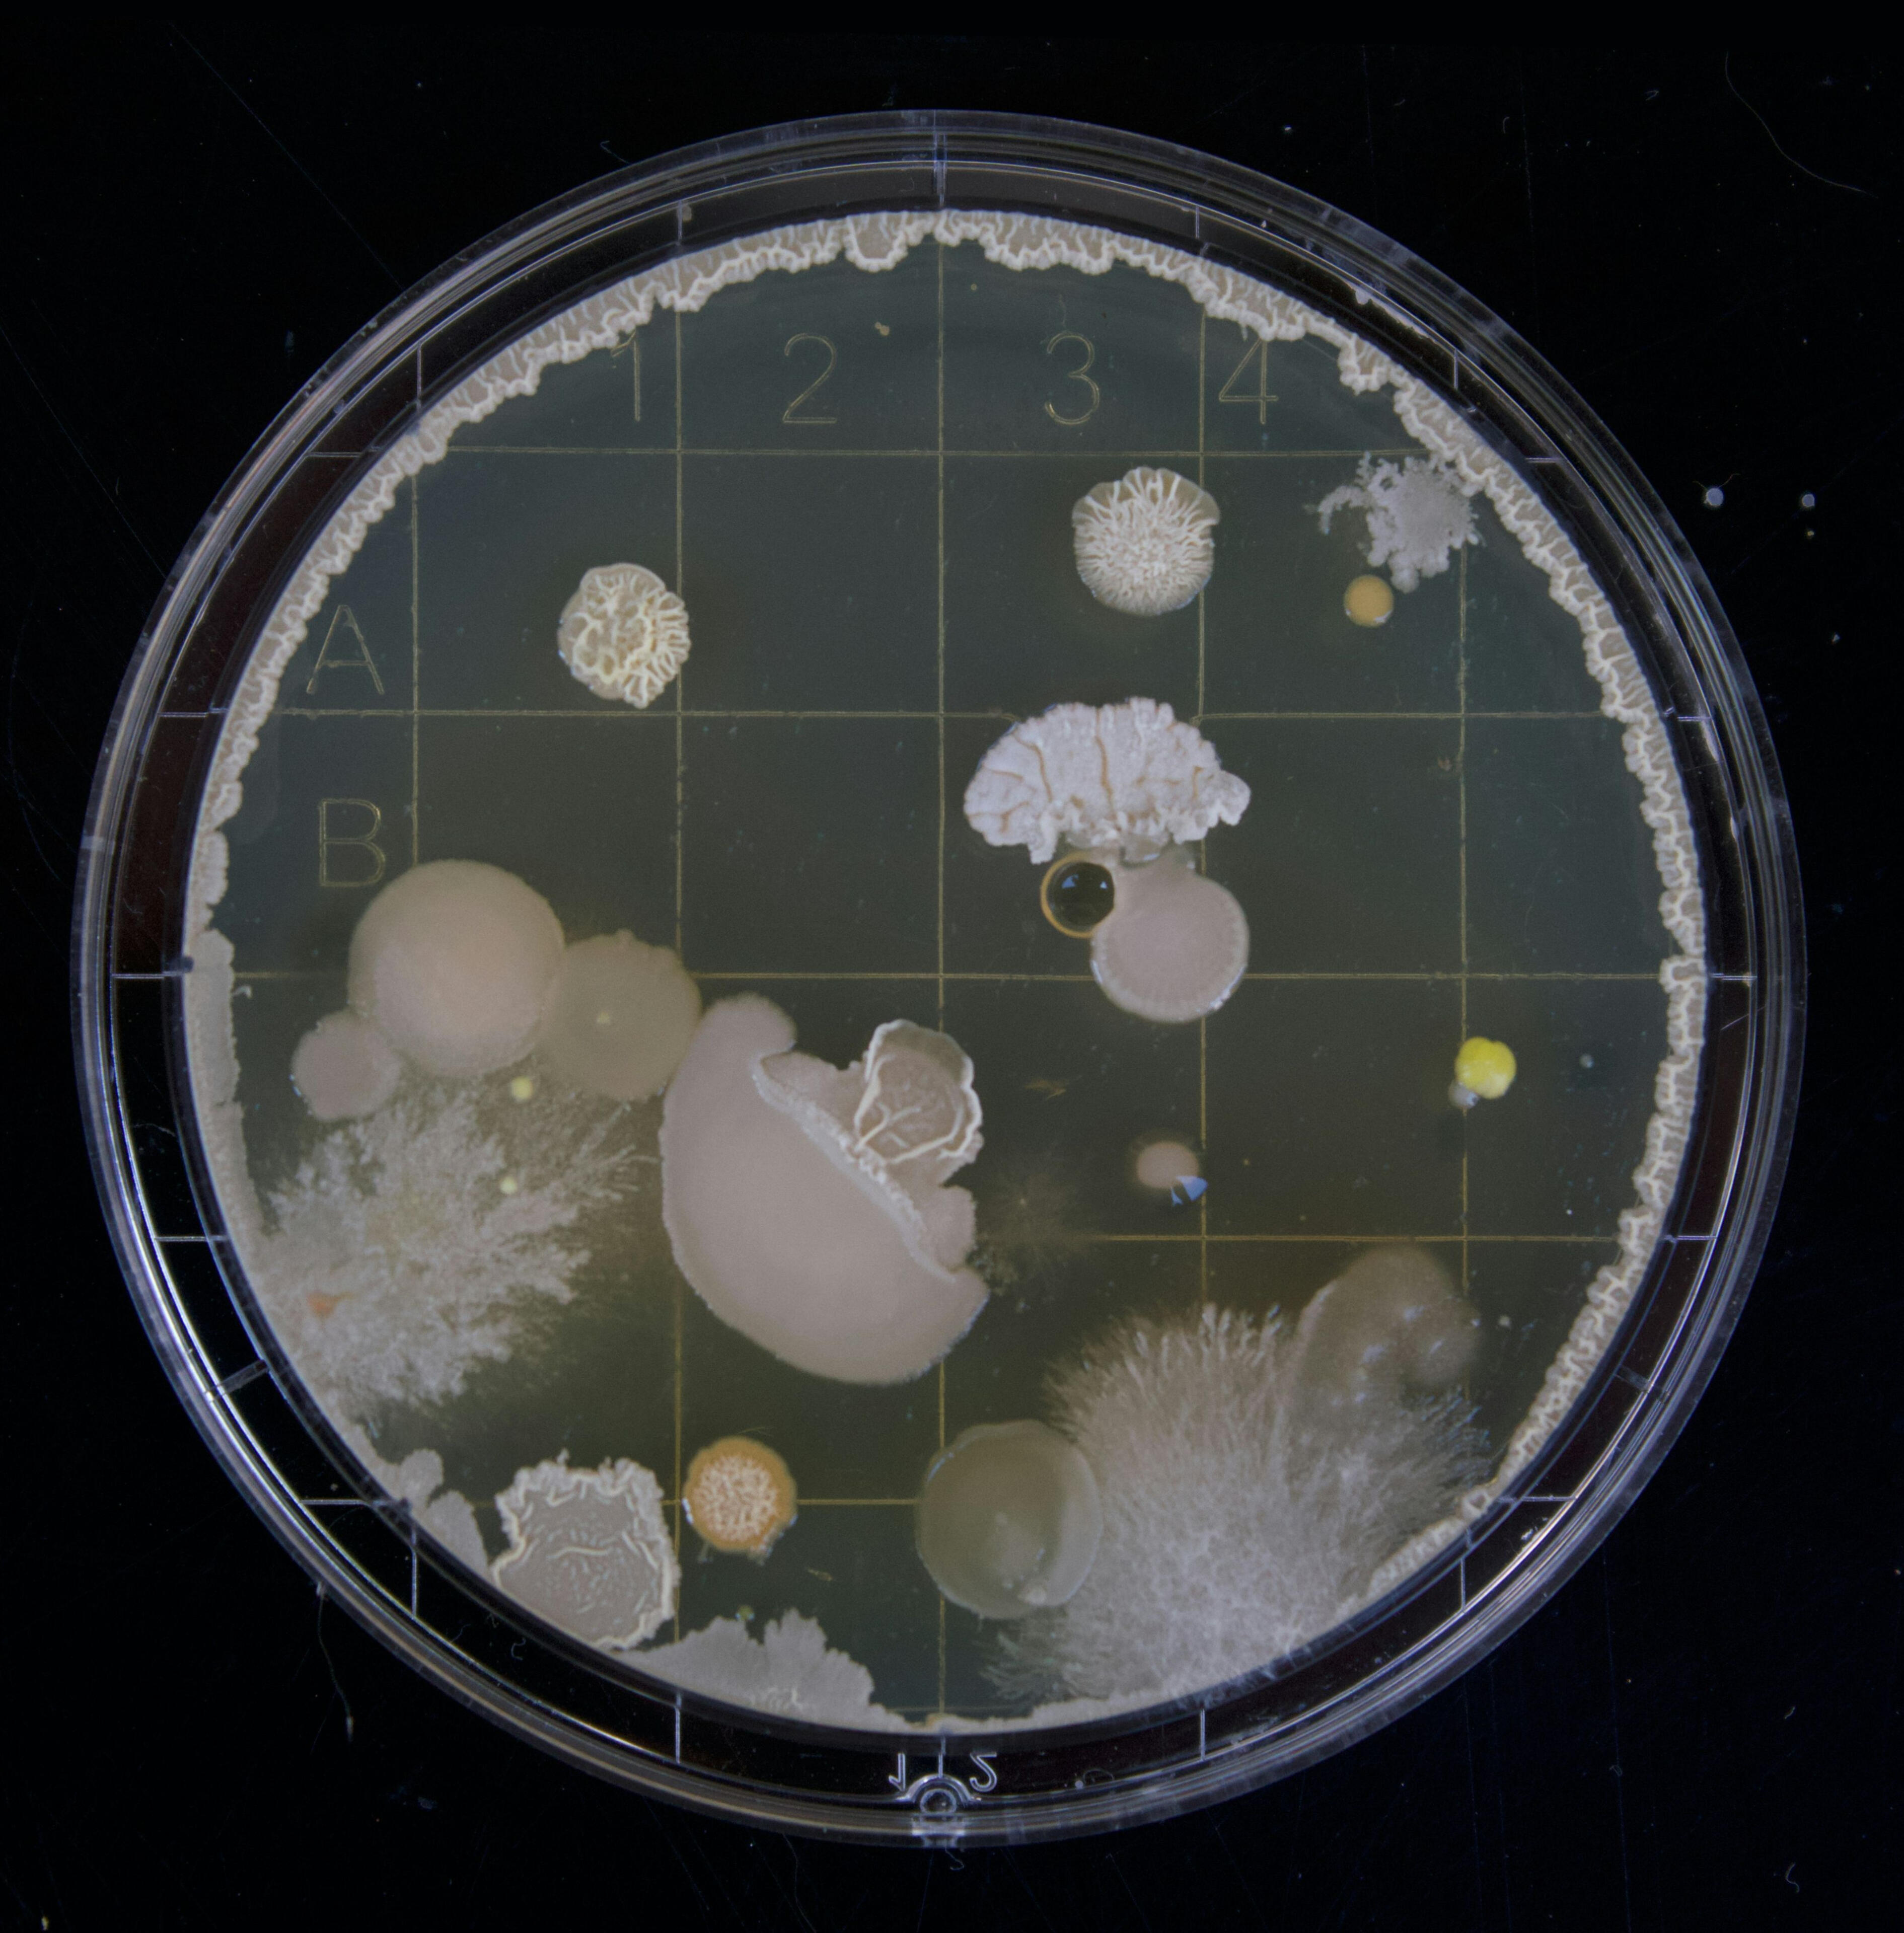

You make your self healthy and we make your home healthy. We remove the PFAS, pthalates, heavy metals, and fluoride from your water, as well as the mold and or EMF radiation from your home's air. All work done by licensed and insured professionals. Let's get it done.Send us a message to see what we can do for you.

Water
As an herbalist and a plumber, I watch the trades from a different perspective than other plumbers. Plumbing is the trade associated with health which is one reason I chose it. Most plumbing these days is with pipe called PEX, Poly, and PVC. Which means it is all plastic. The evidence is undeniable and science knows the detrimental hormonal effects of the pthalates and xenoestrogens that end up in our bodies from plastics. This happens especially from the hot side of modern PEX plumbing. Although copper isn't perfect either, we offer copper replacement to these PEX pipes so we at least don't have to worry about the endocrine disruption that comes from PEX. With all budgets from partial to full re-pipes of your home, combining copper plumbing with water filtration is the best option in our modern world. Which not only can protect you from the plastic but is an investment for your home in the future. I am going to link below some articles and resources if you want to look into them.
Water
Based on research I like to use a combination of RO (Reverse Osmosis) and charcoal. RO has been proven to take out pthalates and the charcoal to take out chlorine and bacteria or even the pthalates from the plastic filters in the RO system. I prefer to have the charcoal last in line after the RO filters. Those of us in America are concerned with pthalates, PFOS, sodium fluoride and other synthetic substances on top of bacterial or microbial issues. Heavy amounts of chemicals are added to our water to deal with the microbial parasites but then not much is done to remove those chemicals. There are a number of different types of filters but we think the combination of reverse osmosis and charcoal are the best options so you can bathe your family and drink water with some peace of mind. I will link some references and studies below.


Air
The first and best defense against mold is proper ventilation. Homes in the past came with large fans to pull air from outside into the attic, and then blown out the roof. Clear stagnant air during spring and fall to combat "flu" season. We offer whole house and attic fan installation as well as dehumidifiers. Battling mold and dampness in our homes not only improves our health, it is an art and the right tools make it easier. The art is keeping the air flowing, water tight, and dampness out.
Air
"Mold, dust mites, pet dander, and pest droppings or body parts can trigger asthma. Biological contaminants, including molds and pollens can cause allergic reactions for a significant portion of the population. Tuberculosis, measles, staphylococcus infections, Legionella and influenza are known to be transmitted by air." https://www.epa.gov/indoor-air-quality-iaq/what-are-biological-pollutants-how-do-they-affect-indoor-air-qualityWe offer two primary types of UV systems for AC units: coil-sanitizing lights and air-sanitizing (in-duct) lights. To destroy mold living in your AC systems that contribute to disease.

Ether
Electromagnetic radiation is everywhere in our modern world. The newest 5g radiation is the most toxic so far. Not only is there radiation from cell phone towers, even our wifi and smart appliances emit RF throughout our homes and bodies all day. EMF shielding fabric is available to be applied in certain rooms or every room if you wish.On top of EMF shielding, it is possible to make a home wired instead of wire-less with a reintegration of cat-5 or 6 cables to connect to the internet without radiating our bodies or our families with WIFI. I will link below some studies on EMF but if you need real proof, just put a house plant right next to your wifi router and watch what happens over the next couple of weeks.